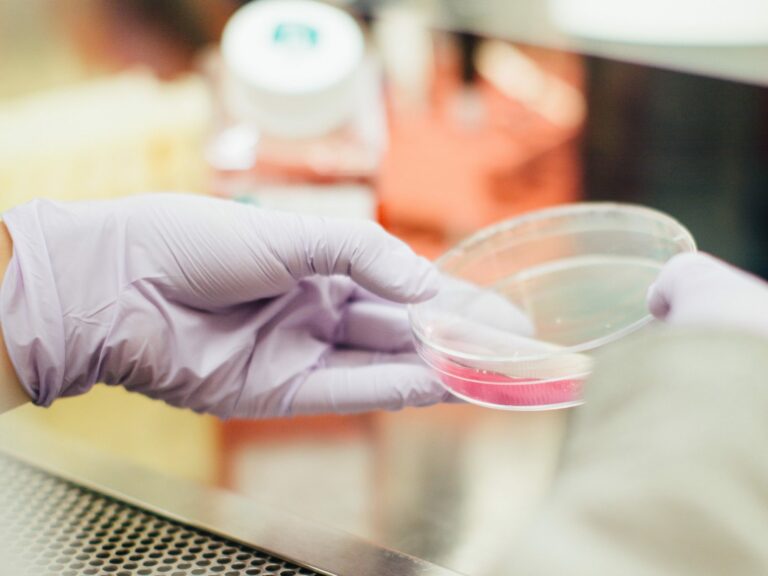
A hand doing a test in a petri dish

Understanding group B streptococcus
Group B Strep (Group B Streptococcus or GBS) is a bacteria that is very common and usually harmless to healthy adults. However, it can be dangerous when a pregnant woman is carrying Group B Strep because it can be harmful to her unborn child.
Group B Strep causes a risk, albeit low, of miscarriage, and it can be dangerous if a baby comes into contact with the bacteria during labour – it can cause serious injuries or even be fatal. If GBS is found during your pregnancy or if you have had a baby affected by GBS in the past, you should be offered antibiotics in labour to reduce the risk to your baby.
Midwives and obstetricians should be aware of the risk factors for GBS infection and the signs of it. It should be treated with antibiotics straight away. If there were failures of medical staff to identify or act upon GBS infection risk factors or symptoms in your case it could mean it was avoidable, but deciding for certain involves close inspection of each specific case.